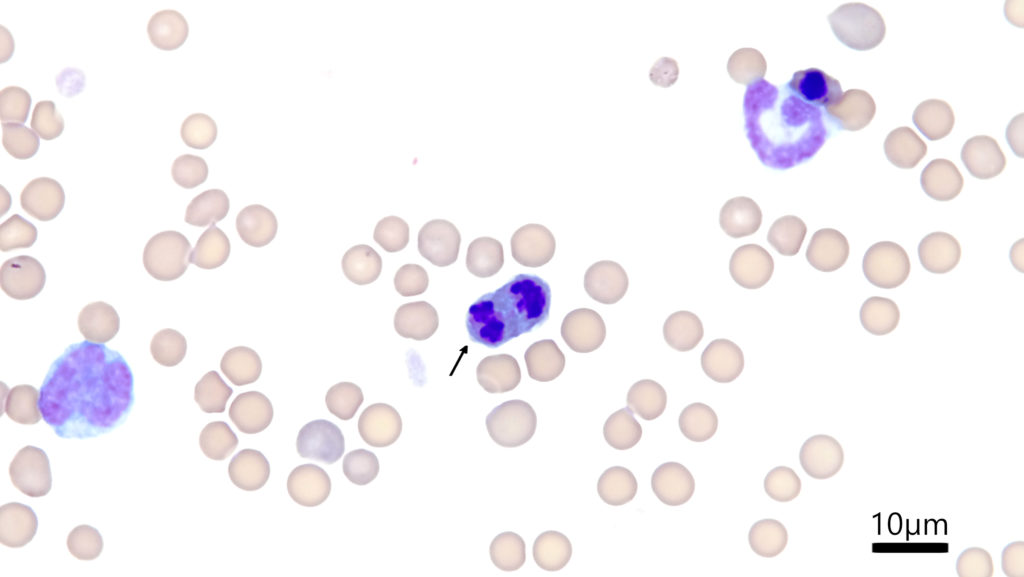
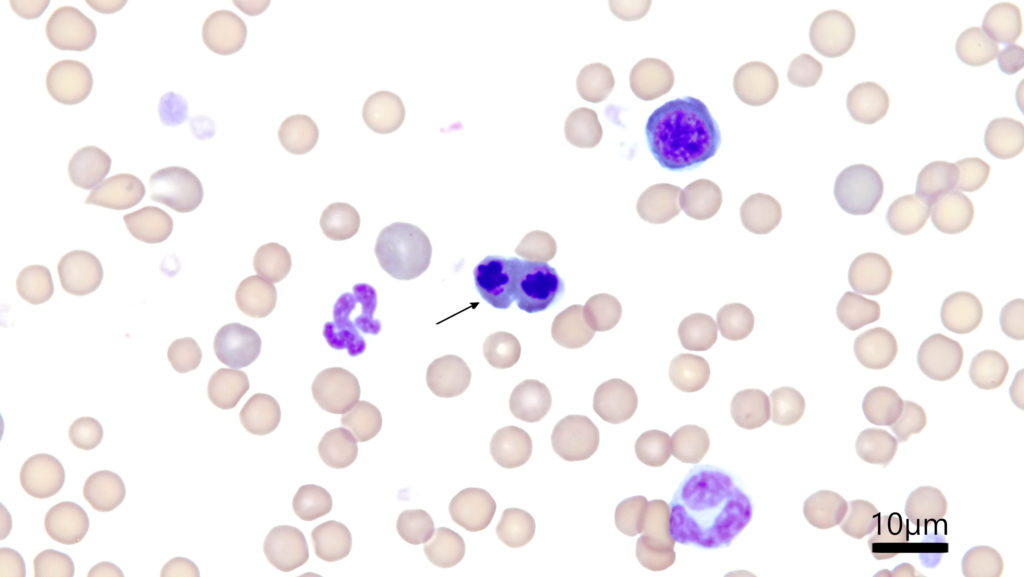

顕微鏡写真: 猫の赤芽球の有糸分裂像
有糸分裂をはじめて習ったのは高校生物だったような気がします。でもその頃の記憶はあまり無く、きちんと勉強したのは浪人生になってからでした。M期は前期、中期、後期、終期にわかれたり、G1期、S期、G2期とか。今回記事を書くにあたって英語の文献を少し見ていましたが、細胞分裂に関する用語が不慣れすぎて理解に苦しみました。
M期がMitotic stageであることは想像できていましたが、前期はProphase、中期はMetaphase、後期はAnaphase、終期はTelophaseって言うんですね。Telo-という接頭辞は「終わり」、という意味を指すらしいです。Telomereとか確かにそんな使われ方をしていそうな。しかしAna-という接頭辞は「後ろ」よりも「上」、とかの方が良く出てきていて、Anaplastic(未分化)という単語が腫瘍ではよく出てきたりするので今ひとつAnaphaseは馴染みづらそうです。
閑話休題。今日は猫の赤芽球の有糸分裂像です。赤血球を盛んに合成している骨髄中ではよくみられる像ですが、今回は末梢血でみられていました。
上記のMitotic stageの分類的にはこれは後期、Anaphaseかなぁ。
そしてこちらはくびれが出てきているので終期、Telophaseでしょうか。いずれも生物の専門家の方に正解を教えて頂きたい。

最後の写真はおそらく異常な核分裂像だと考えています。この症例は重度貧血の子でしたが白血病など腫瘍性疾患ではなかったので、過剰に造血を頑張った結果、このような異常な細胞分裂像を含めた分裂途中の赤芽球が末梢に放出されてしまったように考えています。
何とかしてこのような赤芽球を正しく骨髄で成長させて成熟赤血球を沢山放出できるように治療方針を考えるのですが、中々それが難しく。顕微鏡越しに血球たちにせっつかれる日々ですが、引き続き精進していきたいと思います。


